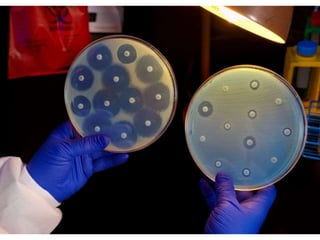

El documento describe los requisitos y procedimientos para realizar un urocultivo, incluyendo la recolección de la muestra de orina, los medios de cultivo utilizados, la siembra y el crecimiento bacteriano, y la importancia de los antibiogramas para guiar el tratamiento.